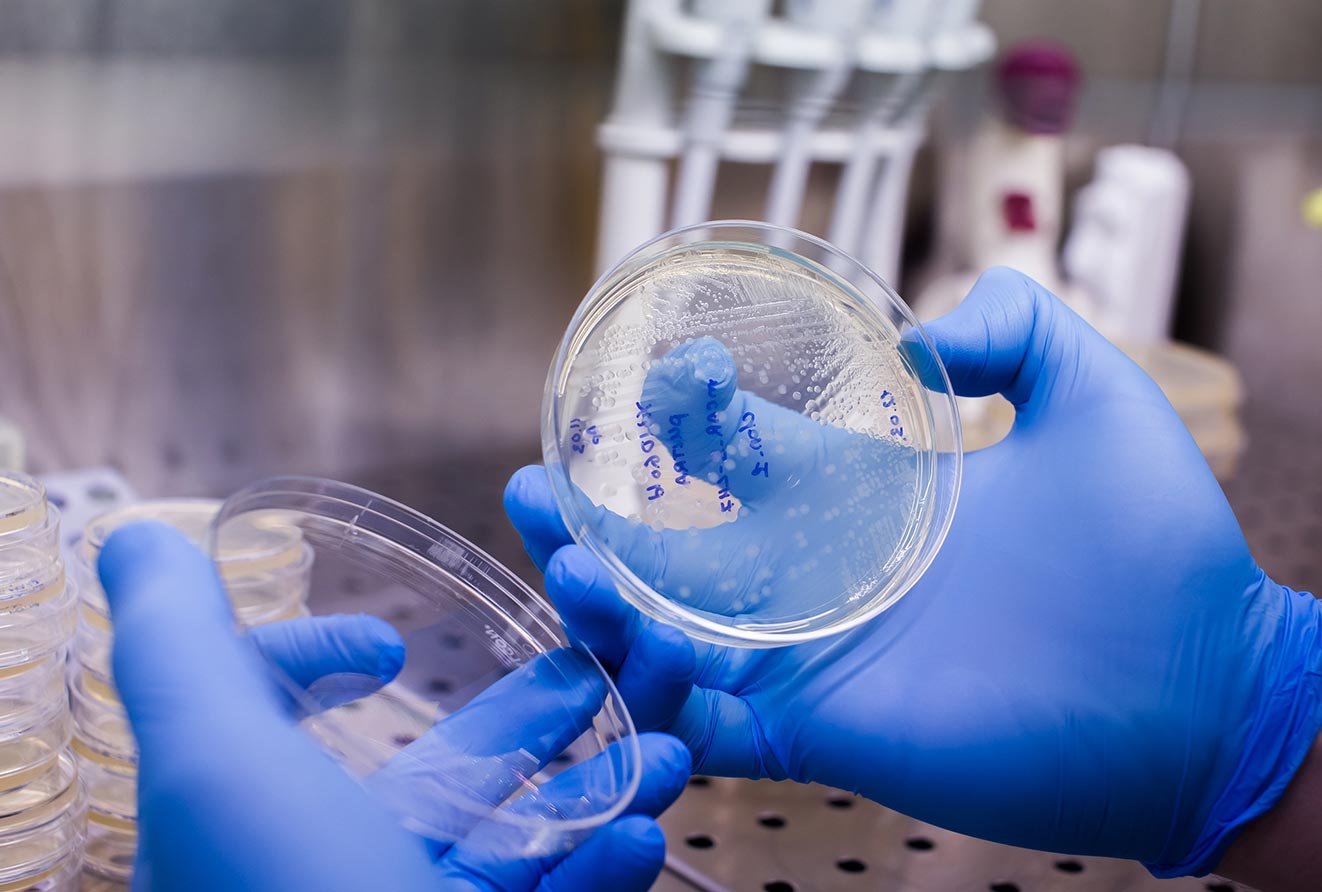
CAR-T cells agence cabinet conseil consulting

Articles
Oral delivery of macromolecules: Big Pharma keep searching for the Holy Grail
Representing 9 out of the top 10 income-generating products on the market, biological drugs are now undoubtedly the main growth driver for the pharmaceutical industry. Big Pharma are looking not only ...